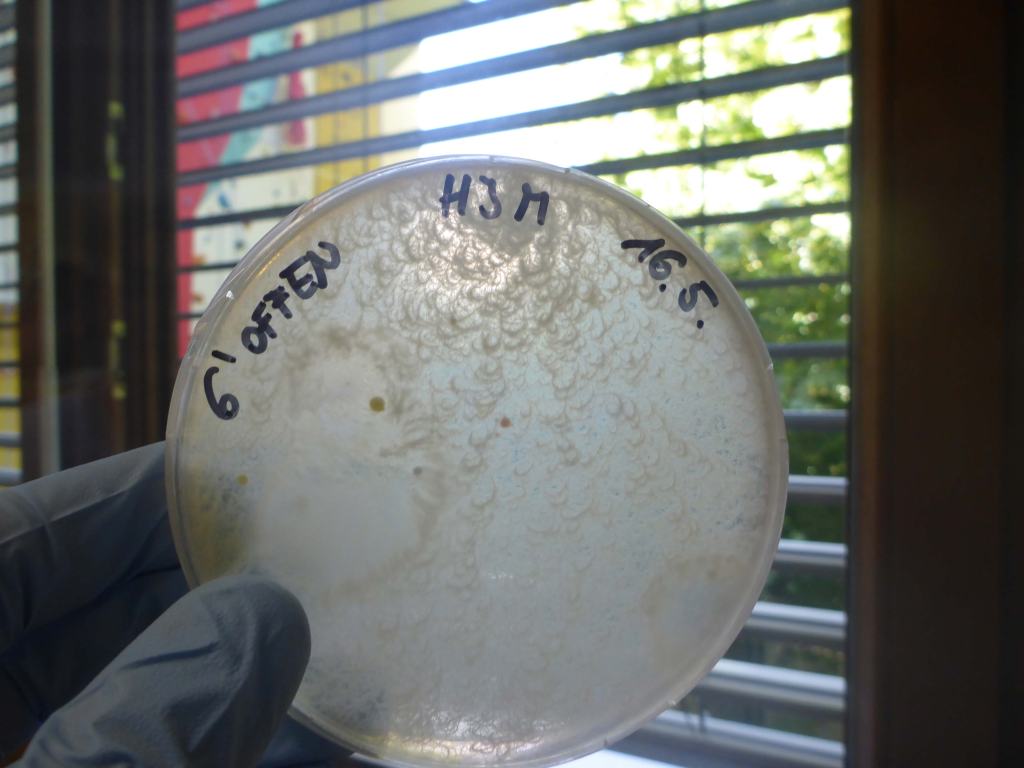
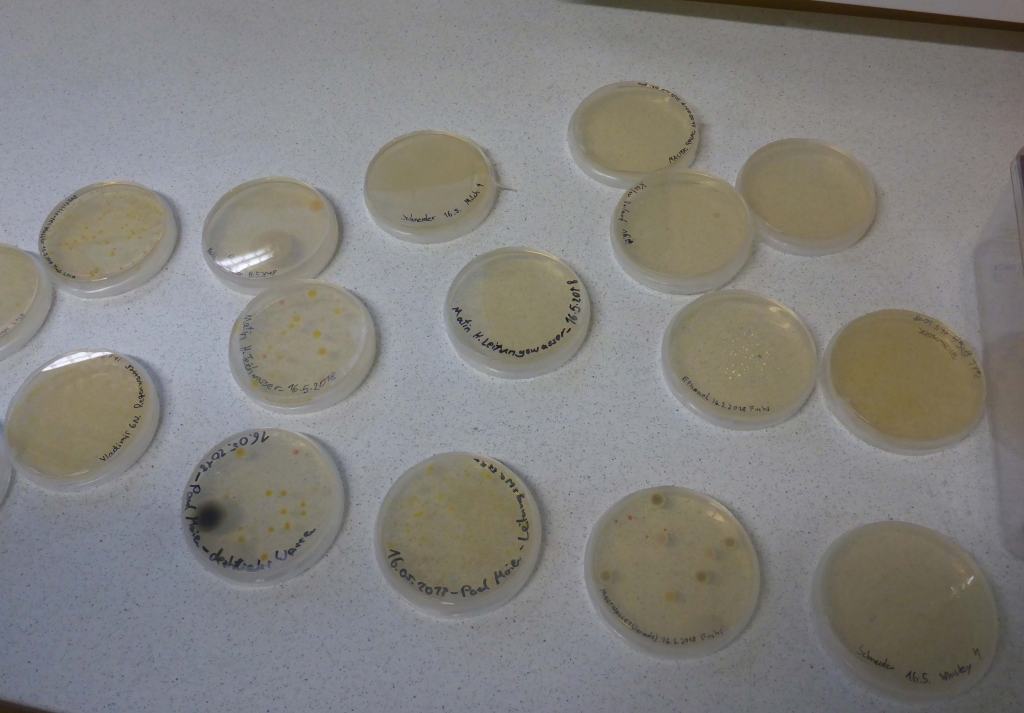

Am 28.5. war das Projektteam erneut am Gymnasium der Herz-Jesu-Missionare in Salzburg in der Klasse 6n zu Gast. Zunächst wurde in einem Vortrag besprochen, was nun Bakterien eigentlich auszeichnet und welche Bedeutung sie für uns Menschen haben. Dann ging es ans praktische Arbeiten. Jeder hatte eine Probe aus einem Gewässer mitgebracht und die wurden nun zuerst filtriert und dann auf Agarplatten mit verschiedenen Nährstoffzusammensetzungen ausgestrichen. Wir hoffen, dass durch diese zwei Tricks möglichst viele unbekannte Arten auf den Platten wachsen werden. Das möglichst sterile Arbeiten und der Umgang mit Pipette, Spatel und Parafilm 🙂 ging nun schon sehr gut. Die Platten wurden genau beschriftet, das ist sehr wichtig, damit wir bei den inzwischen mehreren hundert Platten aus dem Schulprojekt nicht den Überblick verlieren.









Im zweiten Teil wurden die Agarplatten, die im ersten Workshop bearbeitet worden waren, begutachtet. Die meisten hatten mit ihrer Einschätzung richtig gelegen, im Wisky sind tatsächlich keine Bakterien 🙂

Mir gefiel das viele praktische Arbeiten und dass wir immer wirklich kurz und prägnant die Theorie zur jeweiligen Einheit bekommen haben. Außerdem war es sehr schön, unsere heranwachsenden Kulturen zu sehen. Nick Beger
Es war eine sehr intressante und spannende Erfahrung. Wir haben viel experimentiert und wir sind auf faszinierende Ergebnisse gestoßen. Alessandro Butturini

